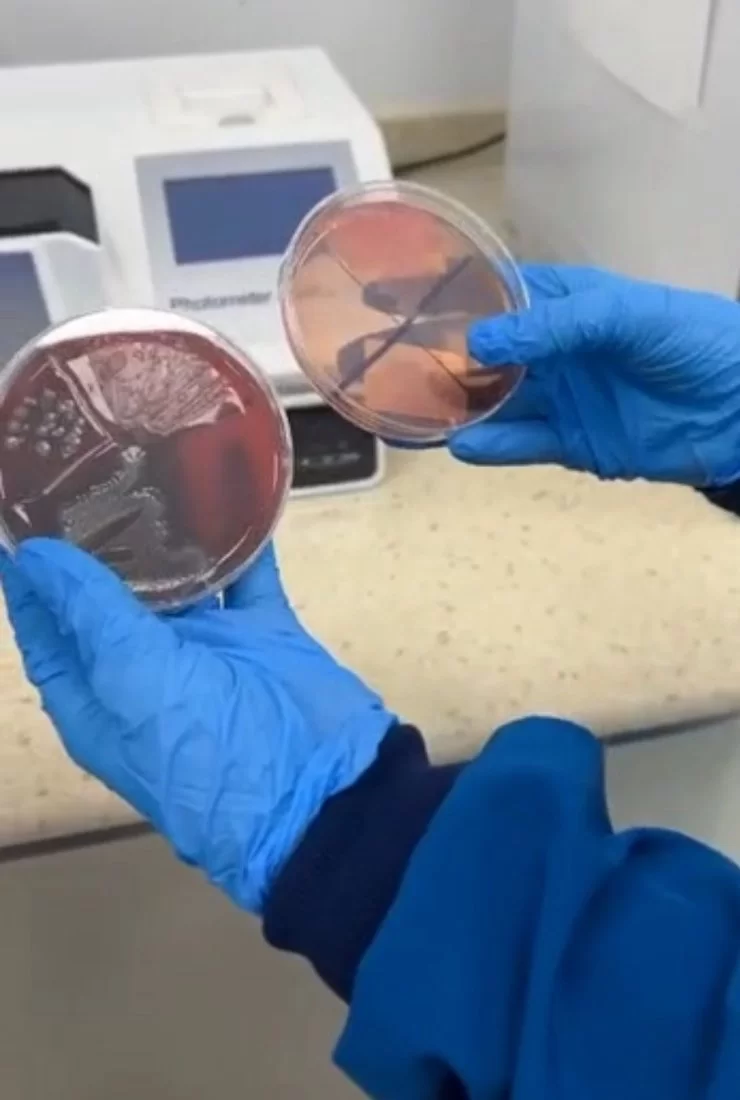

زيارة علمية ميدانية إلى مجمع عيادات الرباط في بلدية تاجوراء
نظّم قسم الأحياء بتاريخ 2/ 12/ 2025م. زيارة علمية ميدانية إلى مجمع عيادات الرباط في بلدية تاجوراء؛ وهدفت الزيارة إلى دعم الجانب النظري بالجانب التطبيقي.كان في استقبال الوفد الأكاديمي السيد\ د. أيمن بالقاسم والسيد/ عز الدين بالقاسم (المسؤولان عن المجمع)، برفقة الدكتورة آية والدكتورة آلاء (المختصّتان في وحدة المعمل).تم تقسيم الطالبات إلى مجموعتين لضمان أقصى استفادة وتفاعل خلال الزيارة التي تضمنت التعرف الشامل على الأجهزة والمواد التشغيلية المستخدمة بشكل روتيني في المختبر: - التعرف على فصائل الدم (Blood Grouping) وإجراء تحاليل روتينية لعينات صورة الدم الكاملة (CBC) وعينات البول (Urine Analysis).- التدريب على سحب الدم (Phlebotomy): تم شرح الآليات الصحيحة لإجراء عملية سحب عينات الدم بأمان ودقة.- التقنيات الأساسية: التعرف على أنواع المزارع البكتيرية (Bacterial Cultures) وطرق تحضيرها ومعالجتها.- شرح آلية عمل جهاز الطرد المركزي (Centrifuge)�- الاختلافات بين أنواع أنابيب الاختبار المخصصة للتحاليل المختلفة. - شرح مبدأ عمل الماصة الإلكترونية (Electronic Pipette). - التعرف على آلية عمل الأجهزة الحديثة وقدرتها على قراءة وتفسير نتائج التحاليل إلكترونياً.يُعرِب قسم الأحياء عن خالص شكره وامتنانه لإدارة مجمع عيادات الرباط على حُسن الاستقبال والتعاون المثمر الذي ساهم في إثراء الجانب المعرفي للطالبات.

التعليقات